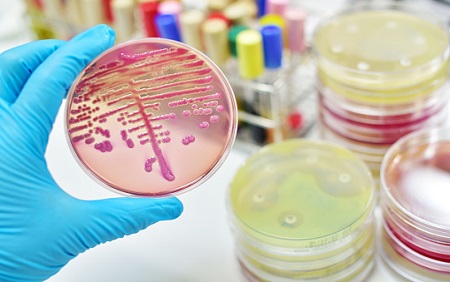

News

U.S. News & World Report Names Beth Israel Deaconess Medical Center Among Best Hospitals for 2025-2026 in Massachusetts
Beth Israel Deaconess Medical Center named a 2025–2026 Best Hospital by U.S. News, ranking top 50 in 9 specialties and earning 19 high-performing ratings.
Jul. 29, 2025
Read More About: